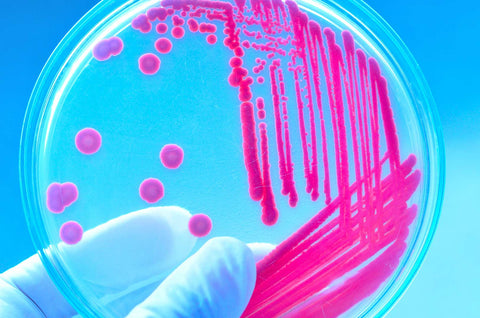
What’s the Difference Between Resident and Transient Strains?

Moyeu d'origine
-
Catégorie
- Aliments Verts
- Probiotiques
- Prébiotiques
- Collagène
- Omégas
- Nutrition sportive
- Enfants
-
Type de repas
- Collation
- Bol à smoothie
-
Restrictions diététiques
- Végétalien